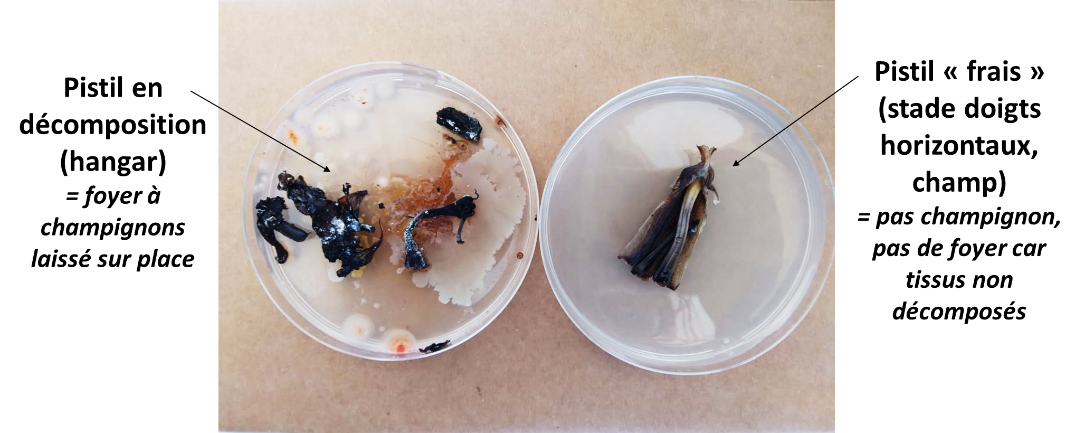

Comment assurer la protection des bananes contre les maladies de conservation ?
Les maladies de conservation (MDC) de la banane sont des affections fongiques complexes, résultant de l'interaction de multiples facteurs, qui occasionnent des pertes économiques considérables pour la filière banane aux Antilles — jusqu'à près d’un million d’euros. Elles se traduisent principalement par l’apparition de pourritures au niveau de la couronne, du pédoncule et de l’épiderme du fruit, rendant ce dernier impropre à la vente.
Ces pourritures sont provoquées par une diversité d’agents pathogènes (tels que Colletotrichum musae, Lasiodiplodia theobromae, etc.), présents aussi bien dans les parcelles de production qu’en station de conditionnement.
La contamination des bananes peut donc survenir à différents stades de la chaîne de production, et leur développement est favorisé par les conditions d’humidité, les blessures mécaniques et la durée du trajet en bateau, qui peut varier entre 10 et 14 jours. Cependant, les symptômes ne deviennent généralement visibles qu’après le transport maritime à l’arrivée au port de Dunkerque ou lors du mûrissage en station, entraînant alors l’élimination d’un nombre important de colis, avec pour conséquence la perte directe d’une partie significative de l’effort de récolte.
Face à cette problématique, la stratégie de lutte repose sur la mise en place de pratiques agroécologiques en amont de l’expédition, telles que le tri rigoureux des régimes, la maîtrise de l’hygiène post-récolte, l’amélioration des conditions de transport et le recours à des traitements alternatifs aux fongicides de synthèse.
1. Que sont les maladies de conservation de la banane ?
1.1. Trois composantes des maladies de conservation : pourritures de couronnes, pédoncules et d'épiderme


Les pourritures de couronnes sont l’expression visible d’infections fongiques provoquées par un grand nombre de champignons présents sur les débris de culture des bananiers. Parmi les genres les plus fréquemment identifiés, on retrouve Colletotrichum musae, agent du chancre, ainsi que différentes espèces de Fusarium, Verticillium et Cephalosporium.
Ces champignons contaminent les coussinets floraux des bouquets en pénétrant les tissus végétaux par les plaies ouvertes lors de la découpe des mains en bouquets. Les eaux de lavage, lorsqu’elles sont mal renouvelées ou mal désinfectées, constituent une source majeure de dispersion et de concentration des spores, favorisant ainsi la propagation de ces pathogènes.
Le chancre (aussi appelé Anthracnose) est une pourriture de la peau des fruits provoquée par une seule espèce de champignon : Colletotrichum musae. Pouvant infecter le fruit au champ, principalement durant le premier mois qui suit la jetée, ce champignon possède la particularité de former rapidement des structures "dormantes" et très résistantes qui restent fortement accrochées à la surface des fruits. Ces structures permettent au champignon de résister aux agressions du climat et aux traitements fongicides. Le chancre se développe pendant les phases de transport et de mûrissage à tous les endroits où l’épiderme des fruits aura été endommagé là où des structures dormantes sont présentes. En absence de blessures, le champignon se développe après le mûrissage, fragilise l’épiderme du fruit et induit le raccourcissement de la durée de vie commerciale des bananes en cas de forte infestation.


Parmi les pourritures affectant la peau des bananes, on distingue deux types principaux :
- Les pourritures de l’épiderme, qui peuvent apparaître sous forme de taches noires localisées sur différentes parties de la peau et parfois s’étendre à l’ensemble du fruit.
- Les pourritures du pédoncule, qui concernent la zone terminale reliant chaque doigt au rachis (tige principale du régime), et se traduisent par un ramollissement, un noircissement ou l’apparition de moisissures au niveau du pédoncule, pouvant conduire à la chute prématurée du fruit. D’autres agents pathogènes tels que Lasiodiplodia theobromae, des espèces de Fusarium, voire Thielaviopsis paradoxa, sont fréquemment associés aux pourritures du pédoncule, car identifiés dans les zones atteintes, mais ils ne suffisent pas à expliquer seule l’apparition des symptômes.
Type de pourriture |
Zone affectée |
Agents fréquents |
Symptômes caractéristiques |
Impact principal |
| Couronne | Zone de découpe (couronne) | Colletotrichum musae, Fusarium, Verticillium et Cephalosporium | Noircissement de la coupe, pourriture ascendante | Contamination interne |
| Pédoncule | Attache du doigt | Colletotrichum musae | Ramollissement, chute des doigts | Perte physique du fruit |
| Epiderme | Peau du fruit | Taches noires, nécroses cutanées | Rejet à la vente |
Source : Manuel du planteur
1.2. Pourquoi est-ce problématique ?
Quels sont les agents causals ?
Les champignons responsables des maladies de conservations sont de nature insidieuse et ubiquitaire. Présents dans les champs, mais également dans les stations de conditionnement (hangars) et surfaces de stockage, leur contrôle reste très difficile. Ces pathogènes peuvent rester latents ou invisibles lors de l’emballage, donnant l’apparence de fruits sains, puis se développer pendant le transport et la conservation, entraînant l’apparition tardive de taches, pourritures ou ramollissement. Dans ces conditions, la contamination peut se propager rapidement au sein d’un lot, compromettant la qualité globale des fruits. Ces caractéristiques expliquent pourquoi les MDC constituent non seulement un risque de non-conformité réglementaire, mais également un risque économique direct, générant des pertes de produits, des déclassements et des surcoûts liés au tri et à la destruction. Le document ci-contre édité par l'IT² les décrit et apporte des informations complémentaires.
Rappel du cahier des charges européens
La commercialisation des bananes destinées au marché européen est encadrée par des normes strictes qui visent à garantir la qualité des fruits proposés aux consommateurs. Selon les normes CEE/ONU FFV-29 et le Règlement (UE) n° 543/2011 relatif aux normes de commercialisation, les fruits doivent parvenir sur le marché verts, fermes, exempts de pourritures et de tout défaut altérant leur aspect ou leur intégrité. Le respect du grade de qualité implique notamment l’absence de taches importantes ou de dégradations liées aux maladies post-récolte.
Conséquences : calcul du taux de MDC, non conformité, coûts de tri, pénalités
Pour évaluer la conformité des lots de bananes à l’égard des maladies de conservation (MDC), le calcul du taux de MDC correspond à la proportion de fruits présentant des défauts post-récolte visibles comme des taches, pourritures ou chancres. Selon les bonnes pratiques, un taux de MDC inférieur ou égal à 1 % est considéré comme acceptable ; entre 1 % et 2 %, il représente une zone de vigilance ; au-delà de 2 %, la qualité du lot est jugée non maîtrisée.
Lorsque le taux de MDC est supérieur au seuil d’acceptabilité, les conséquences peuvent être multiples au regard des normes européennes :
- Le lot peut être déclassé ou refusé, entraînant potentiellement destruction, tri, retour ou orientation vers un marché de moindre valeur.
- Des coûts logistiques et financiers élevés sont engagés, liés au tri, transport, la destruction ou la perte potentielle de contrats.
- La réputation de l’opérateur peut être compromise vis-à-vis des acheteurs et distributeurs, avec un risque de réduction des commandes futures.
2. Comment assurer la protection des fruits contre les maladies de conservation (MDC) ?
Les champignons responsables des maladies de conservation (MDC) sont ubiquitaires, présents à la fois dans les champs et dans les hangars. Afin d’assurer la protection des fruits contre les MDC, les actions mises en place par l’IT2 interviennent successivement depuis la culture jusqu’à l’expédition, en combinant prévention, maîtrise physiologique et mesures post-récolte adaptées. Ci-contre, un guide et une vidéo détaillent les bonnes pratiques à mettre en place en Guyane notamment.
L’objectif principal est de maîtriser une partie du cycle de développement des agents causaux, en limitant, voire en empêchant, l’accès du champignon à ses besoins fondamentaux : source de nutriments (nutrition), site d’infection ou point d’ancrage (foyer), moyen de dispersion (transport), conditions favorables au développement (confort).
Pour ce faire, les moyens de lutte, issus de diverses expérimentations, des retours de producteurs, de missions à l’étranger ainsi que de veilles technologiques et bibliographiques, ont permis d’identifier quatre axes principaux sur lesquels agir pour prévenir, anticiper et mieux gérer les MDC.
- Sensibilité du fruit : Certains facteurs rendent les fruits plus vulnérables aux maladies : ratio feuilles/fruits défavorable, non-respect du point de coupe, mauvais état des traces (routes) ou manipulations brutales au déchargement. Les solutions consistent à renforcer la physiologie des bananiers et la résistance des fruits : gestion de la cercosporiose pour maintenir des feuilles fonctionnelles, castration à six mains, fertilisation adaptée, engainage et manipulation délicate des régimes.
- Source d’inoculum : Les MDC sont présentes à la fois en plein champ et en station de conditionnement. Elles peuvent se déposer et se multiplier sur le matériel végétal, les outils de découpe ou dans l’eau contaminée. Les leviers consistent à éliminer ou réduire ces foyers : épistillage, désinfection du matériel, gestion de la qualité de l’eau (chloration, flux continu d’eau propre), rinçage, traitements fongicides post-récolte.
- Zones d’entrée des champignons : Les blessures créées lors de la coupe au bananier, du dépattage ou de la découpe constituent des portes d’entrée privilégiées pour les pathogènes. La prévention repose sur l’utilisation d’outils propres/aseptisés, des pratiques de découpe maîtrisées et des soins adaptés aux fruits.
- Conditions favorables au développement des champignons : Certaines conditions après récolte favorisent la propagation des MDC : présence de pistils, eau contaminée, humidité excessive, atmosphère inadaptée. Pour limiter le développement des maladies, plusieurs pratiques sont efficaces : élimination des pistils, séchage des fruits, aspiration sous vide (Banavac), emballage adapté, refroidissement rapide (mise en froid).
| Activités | Sensibilité du fruit | Source d'inoculum | Zones d'entrée pour les champignons | Condition favorable au développement des champignons |
|
GESTION AU CHAMP |
||||
| o Gestion indirecte des foyers fongiques via la physiologie du bananier | ||||
| 🌱Amélioration de la fertilité des bananiers | ||||
| 🍃Gestion du nombre de feuilles (ratio feuille/fruit) | ||||
| 📅Respect du point de coupe (calendrier, grade) | ||||
| o Gestion directe des foyers fongiques | ||||
| ☂️Gestion des soins aux fruits (engainage et pratiques associées) | ||||
| 🚛Transport des régimes (état de traces) | ||||
|
GESTION EN STATION DE CONDITIONNEMENT (HANGAR) |
||||
|
🚛 Déchargement et manipulation des régimes |
||||
|
🌼 Epistillage |
||||
|
🔪 Dépattage et découpe |
||||
|
🚿 Rinçage et qualité de l'eau |
||||
|
🌡️ Séchage |
||||
|
💨Traitement fongicide post-récolte |
||||
|
📦 Emballage |
||||
|
❄️Mise en froid |
||||

La fertilité est un levier majeur pour limiter les maladies de conservation. Un déficit ou un déséquilibre nutritionnel, particulièrement entre la floraison et la récolte, augmente la sensibilité des fruits au chancre. Il est recommandé de maintenir un rapport potasse/azote supérieur ou égal à 2. Ce ratio contribue à renforcer la structure des tissus et à améliorer la résistance des fruits.



Le ratio entre le nombre de feuilles actives et les régimes présents est déterminant pour la qualité et la résistance des fruits. Un déséquilibre, avec trop peu de feuilles, affaiblit la plante et rend les régimes plus sensibles aux contaminations fongiques. La gestion du feuillage doit donc être rigoureuse afin de maintenir un rapport optimal, garantissant des conditions physiologiques favorables et une meilleure conservation post-récolte.
Les ressources sur la gestion du nombre de feuilles :
- Maîtrise de la physiologie au champ - IT²
- La position de la main sur le régime et le ration source-sink influencent la probabilité de pourriture des couronnes en banane - Article scientifique Cirad (en anglais)
- Maladies de conservation des bananes et leur contrôle - Article scientifique University of Arkansas (en anglais)

Une récolte trop tardive, dépassant 900° jours, expose les fruits à une sensibilité accrue aux MDC. Le respect des avertissements de récolte basés sur les sommes de températures est essentiel. Le marquage doit être réalisé au stade « tête de cheval » et au plus tard à la « dernière main horizontale ». Le grade optimal est de 32 mm. L’organisation des coupes doit viser 50 % des régimes récoltés dans la semaine prévue, 20–30 % la semaine suivante, et 20–30 % issus de la semaine précédente. Cette gestion précise réduit les écarts de maturité, améliore l’homogénéité des lots et limite l’incidence des maladies post-récolte.
Les mesures prophylactiques au champ sont essentielles pour limiter la dissémination du champignon Colletotrichum musae, responsable du chancre. L’engainage réalisé avant la dernière main horizontale, associé à l’élimination systématique des bractées, cravates, vieilles feuilles et parapluies, réduit fortement les sources d’inoculum. La qualité de pose de la gaine, attachée au-dessus de la cicatrice, évite la formation de poches d’eau et freine le ruissellement contaminant. Ces gestes techniques, simples mais déterminants, créent un environnement défavorable au développement des MDC et doivent être strictement respectés.

Le transport et le déchargement des régimes sont des étapes critiques où se créent de nombreuses meurtrissures. Ces blessures constituent des portes d’entrée idéales pour le chancre, dont le développement est souvent lié à des chocs mécaniques. Un bon état des traces, le contrôle du balancement des régimes, le maintien d’un espacement suffisant en penderie (>65 cm), un remplissage équilibré des bacs et des gestes de dépose soignés sont autant de mesures indispensables. Leur respect permet de réduire significativement les dommages mécaniques et, par conséquent, les risques de maladies de conservation.
Les ressources sur le transport et la manipulation des régimes :

L’épistillage consiste à retirer les pistils présents à l’extrémité des doigts de banane. Leur présence constitue un foyer potentiel de contamination fongique, notamment lorsqu’ils stagnent dans les bacs de lavage. Un épistillage rigoureux, associé à l’évacuation régulière des débris végétaux, limite considérablement les risques de propagation.
Ressource sur l'épistillage :
Maîtrise de la pression fongique au champ - Affiche IT²


Le dépattage et la découpe des fruits sont des étapes sensibles. Une découpe mal maîtrisée, laissant des pointes ou des blessures, favorise l’installation des champignons. Il est donc recommandé d’assurer une découpe nette, réalisée avec des couteaux correctement aiguisés et désinfectés plusieurs fois par jour. Par ailleurs, le dépattage à sec, déjà expérimenté dans certaines exploitations, permet de réduire les contaminations liées à l’eau et d’économiser la ressource. Les essais montrent qu’associée à un traitement fongique adapté (chimique ou biologique), cette méthode permet une réduction significative des pourritures de couronnes, tout en améliorant la durabilité des pratiques.


La gestion de l’eau en station conditionne directement la maîtrise des MDC. L’utilisation d’une eau potable ou peu chargée limite les contaminations au niveau des zones de coupe. Trois configurations sont possibles selon la ressource disponible : circuit ouvert sans traitement si la qualité est satisfaisante, circuit ouvert avec traitement (chlore, ozone, dioxyde de chlore) si l’eau est de mauvaise qualité, ou circuit fermé avec recyclage et désinfection lorsque la ressource est limitée. Un trempage d’au moins 15 minutes est indispensable pour permettre l’écoulement complet du latex, condition préalable à un traitement fongicide efficace.

L’efficacité des traitements fongicides est directement liée à l’état de surface du fruit. L’application sur un fruit encore humide entraîne une dilution de la bouillie et réduit la pénétration des matières actives. Le séchage des fruits avant traitement constitue donc une étape clé, trop souvent négligée, qui améliore significativement la performance du traitement et la conservation post-récolte.


Les traitements pos-récolte représentent une barrière essentielle contre les MDC. Leur efficacité dépend de plusieurs conditions : utilisation d’eau potable pour la préparation de la bouillie, respect strict des dosages, préparation récente (moins de trois jours), et couverture homogène de l’ensemble des doigts. Les techniques employées (trempage, pulvérisation, buses à haut débit ou bas volume) doivent assurer un traitement complet (CF Fiche manuel). L’introduction progressive de solutions biologiques ouvre également des perspectives intéressantes pour limiter les résistances et réduire l’usage des produits conventionnels.
Ressource sur les traitements fongicides post-récolte :
La cabine post-récolte standardisée - Vidéo IT²

L’emballage constitue la dernière étape où la qualité du fruit peut être compromise. Des colis mal formés, bombés ou trop serrés favorisent les chocs et meurtrissures, véritables portes d’entrée pour les champignons. L’utilisation de systèmes d’atmosphère modifiée comme Banavac a démontré son efficacité pour limiter les pourritures de couronnes. Enfin, la mise en froid rapide, immédiatement après la coupe, bloque le développement des champignons à un stade précoce et contribue à prolonger la durée de vie des fruits tout au long de la chaîne logistique.
3. Conclusion et perspectives de recherche et d'innovation
Les maladies de conservation du bananier constituent un enjeu majeur pour la filière post-récolte. Elles compromettent la qualité des fruits, réduisent leur durée de vie et génèrent des pertes économiques importantes. La maîtrise de ces pathogènes repose avant tout sur une gestion rigoureuse et continue de la chaîne, depuis le champ jusqu’au consommateur.
Il est difficile d’identifier une méthode unique comme la plus efficace, car les résultats sont souvent variables selon les contextes, les pratiques et les conditions environnementales. C’est la combinaison de plusieurs leviers – hygiène des pratiques de récolte, désinfection des outils, maîtrise des conditions de transport et de mûrisserie, bonnes pratiques en station – qui permet une gestion optimale des MDC. L’efficacité réside donc dans une stratégie globale et intégrée, associant mesures prophylactiques, innovations techniques et suivi rigoureux.
Afin de consolider la filière et d’améliorer durablement la conservation des bananes, plusieurs axes de recherche et d’innovation se dessinent, allant de l’étude des facteurs physiologiques du bananier à l’évaluation de solutions techniques innovantes. Parmi ces axes on peut retrouver une meilleure compréhension scientifique de l’agent pathogène, du bananier et des méthodes de luttes prophylactiques (fertilisation, épidémiologie, gestion du latex, délai de coupe/mise en froid), une évaluation de nouvelles pratiques au champ (efficacité du NEXY, découpe de la popotte) ou en station de conditionnement (film protecteur PARASEAL, application de rayons UV, de régulateurs de croissance, d’huiles essentielles ou agents de traitements – ozone, chlore, acide citrique, éthanol ou sulfate d’alun ; ou encore le développement d’enrobages comestibles)